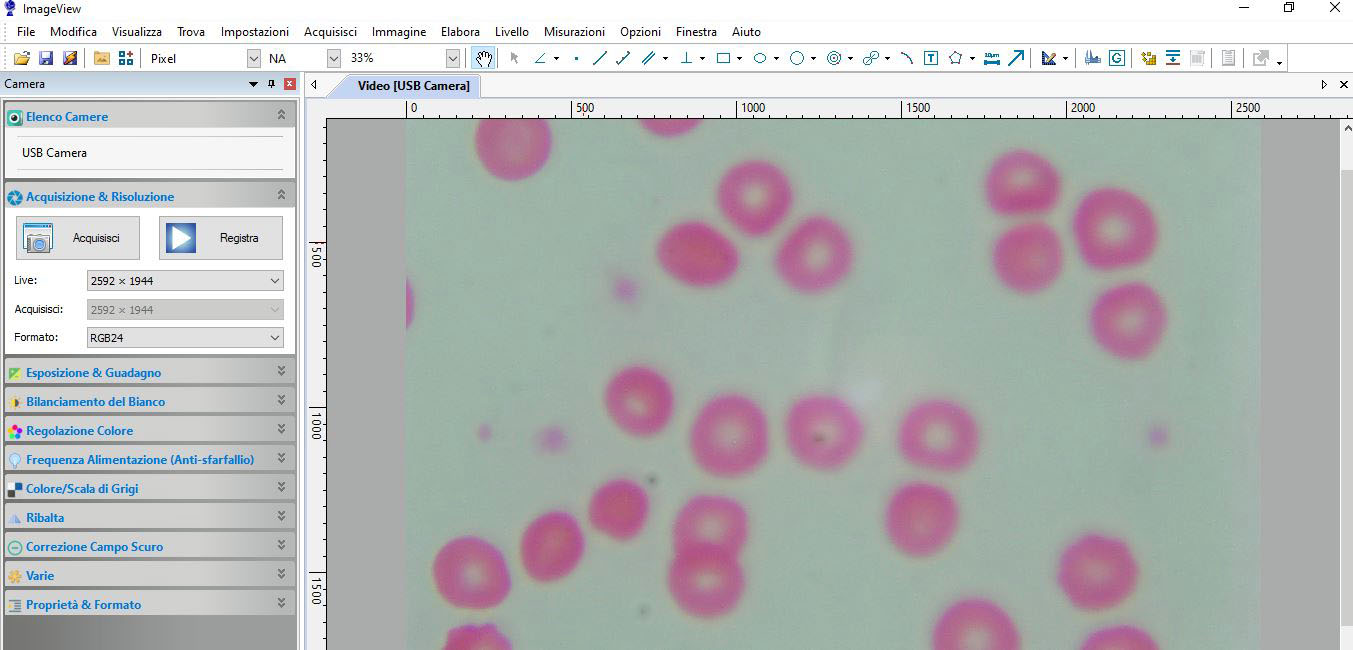
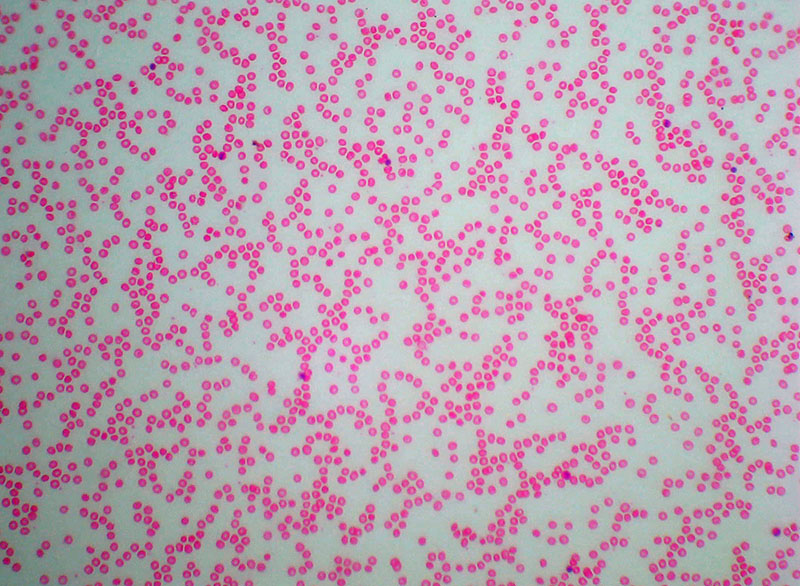

Non hai articoli nel carrello.

Camera per microscopi Tecnosky USB da 5mpx con software in dotazione in italiano
Semplice da usare, si collega direttamente al posto dell'oculare per osservazione ed effettua una riduzione di 0,5x per facilitare la ripresa e la messa a fuoco
In dotazione vengono dati anche due adattattori per microscopi trinoculari

| Codice Prodotto(SKU) | tk_camera_micro5mpx |
|---|---|
| Produttore | Tecnosky |
| Composizione | camera usb,adattattore 0,5x, adattatore per trinoculare |
| Garanzia | 2 anni |
| Disponibilità | In pronta consegna |
